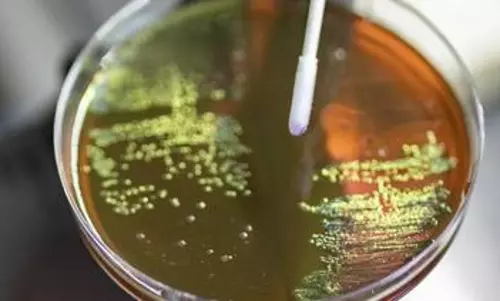
Study finds antibiotic use during pregnancy raise risk of bacterial disease in babies

Punjab to honour corona warrior citizens
text_fieldsChandigarh : Punjab has announced to honour its vigilant residents for observing safety protocols and motivating others to follow them amid the COVID-19 pandemic, officials said on Sunday.
Calling for extra vigil and strict compliance with all protocols, Punjab Chief Minister Amarinder Singh has announced a month-long 'Mission Fateh Warriors' campaign to reward citizens following all health advisories and norms diligently, an official told IANS.
Urging one and all to assume the responsibility for checking the spread of the disease and saving Punjab from its wrath, the Chief Minister said citizens observing all precautions and motivating others to follow safety protocols would be honoured by the state as part of its campaign.
Those following the norms stringently on a daily basis for four weeks will be eligible for a bronze certificate and a T-shirt, while T-shirts along with silver and gold certificates will be given to those adhering to protocols, such as wearing of mask and maintaining social distancing, through the week and month respectively.
All the certificates will bear the Chief Minister's signature.
Registration will begin on the COVA App for competing for the title of 'Mission Fateh Warrior' from June 17.
Those registering on the app would be eligible to earn points every day for following daily precautions, including wearing a mask, washing hands, maintaining safe distance, etc.
Points can also be earned for referrals if they convert into actual downloading of the app or registration for the Mission Fateh Warrior contest.